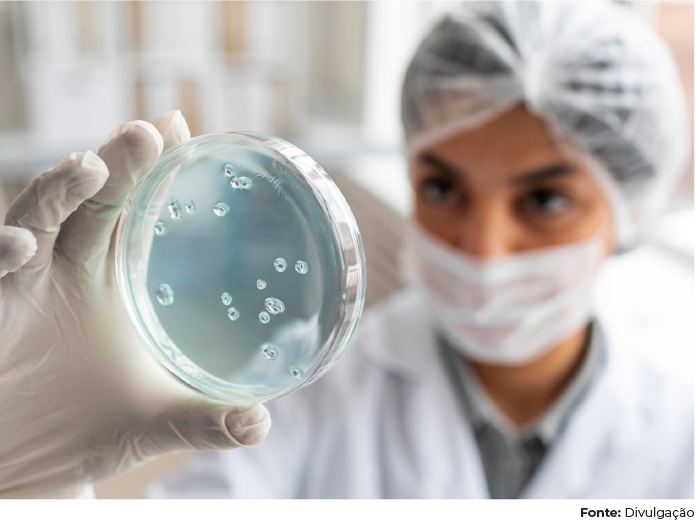

Artigos
SEGURANÇA BIOLÓGICA EM DISPOSITIVOS MÉDICOS
BYPRO MEDICAL DO BRASIL

Por Prof. Dra. Isabela Rodrigues Olívio, Ph.D.
Doutora e Pesquisadora
O objetivo desse parecer técnico-científico é analisar e discorrer sobre os principais critérios adotados pela BYPRO Medical do Brasil para realizar o monitoramento ambiental e microbiológico das Salas Limpas por onde passam todos os dispositivos médicos fabricados !pela!empresa.
SALA LIMPA
Sala limpa, também conhecida
como área limpa, área crítica
ou ambiente controlado,
é um espaço construído para
controlar os níveis de contaminação
ambiental, tanto de
partículas sólidas quanto de microrganismos,
como bactérias
e fungos. O principal objetivo
de uma sala limpa é fornecer
um ambiente controlado onde
a contaminação seja reduzida
ao mínimo. Essas áreas podem
ser destinadas à manipulação
ou produção!de medicamentos,
dispositivos médicos, alimentos
e vacinas, indústria aeroespacial,
centros cirúrgicos e em alguns
casos indústrias de equipamentos
eletrônicos; dispositivos e
produtos que necessitem de
máximo controle das partículas
existentes no ar.
Indústrias que produzem e/ ou comercializam produtos médicos só começam a operar após as salas limpas serem aprovadas em testes de certificação e qualificação. ! Os principais parâmetros seguidos nessa adequação são normas da Agência Nacional de Vigilância Sanitária (ANVISA), normas da Associação Brasileira de Normas Técnicas (ABNT) e normas técnicas do Instituto Nacional de Metrologia, Qualidade e Tecnologia (Inmetro).
Um ambiente controlado deve ser projetado com uma série de características especiais para garantir a manutenção de um ambiente limpo, como:
Controle de partículas: São adotadas medidas para reduzir a quantidade de partículas presentes no ar, incluindo sistemas de filtração de ar, fluxo de ar unidirecional e controle de pressão diferencial. Controle de contaminação microbiológica: São implementadas práticas para evitar a entrada e a proliferação de microrganismos, como sistemas de descontaminação, monitoramento microbiológico e uso de vestimentas estéreis. Controle de temperatura e umidade: O ambiente é controlado para manter níveis adequados de temperatura e umidade.
Limpeza e manutenção: São adotados protocolos rigorosos de limpeza e manutenção, incluindo a utilização de materiais e produtos de limpeza adequados, para garantir a redução da contaminação.
Controle de acesso: São implementadas medidas para controlar o acesso de pessoas e equipamentos à sala limpa, como antecâmara e procedimentos de entrada e saída.
A BYPRO Medical do Brasil projetou e implementou 3 (três) ambientes classificados (Sala Limpa) para oferecer ainda mais segurança e eficácia aos dispositivos médicos que fabrica, sendo eles:
Sala de Embalagem (Classificação ISO 7) – Ambiente utilizado para realizar a termosselagem dos dispositivos médicos;
Sala de Limpeza (Classificação ISO 8) – Ambiente utilizado para realizar o fluxo de limpeza, previamente validado, nos dispositivos médicos;
Sala de Paramentação (Classificação ISO 8) – Ambiente utilizado para realizar o processo de paramentação para o acesso aos demais ambientes controlados.
Nestes ambientes pisos, paredes e tetos foram projetados a fim de garantir o máximo de limpeza e o mínimo de contaminação. O piso assegura limpeza eficiente e manutenção, com cores claras para permitir a visualização de qualquer tipo de sujeira. Rejuntes, trincas e porosidades foram evitadas ao máximo, pois podem acumular microorganismos e contaminantes.
A Sala de Limpeza (ISO8) apresenta pressão negativa, de forma a garantir que o ar de dentro dela seja constantemente retirado e não escape para o ambiente circundante, enquanto a Sala de Embalagem (ISO7) e a Sala de Paramentação (ISO8) apresentam pressão positiva onde o ar é constantemente insuflado para o ambiente interno e impede a entrada de ar não filtrado e elementos contaminantes de ambientes externos. A diferença de pressão entre as salas garante o fluxo de ar no interior da sala limpa.

O fluxo de ar desempenha um papel importante em um ambiente controlado, pois auxilia no fornecimento de ar limpo e filtrado, controla a direção do movimento do ar, remove partículas e contaminantes e proporcionar conforto térmico e controle de umidade.
MONITORAMENTO
MICROBIOLÓGICO
Além dos controles descritos,
visando a máxima segurança
biológica e toxicológica dos
dispositivos médicos, a BYPRO
Medical do Brasil adota uma
rigorosa vigilância ambiental e
microbiológica através de uma



rígida política de monitoramento de partículas viáveis e não- -viáveis.
O monitoramento de partículas viáveis compreende a contagem de partículas em superfície e contagem de partículas no ar ambiente, enquanto o monitoramento de partículas não-viáveis compreende avaliação dos seguintes parâmetros: vazão do sistema e número de trocas de ar por hora, diferencial de pressão, estanqueidade do sistema de filtros, contagem de partículas, temperatura e umidade, iluminação e ruído.
Tanto o projeto técnico das Salas Limpas da BYPRO Medical do Brasil quanto o monitoramento ambiental e microbiológico são realizados por Laboratórios terceirizados, qualificados e com acreditação internacional.
Ambos os monitoramentos mantidos pela BYPRO Medical do Brasil seguem uma periodicidade sistematicamente controlada e que segue rígidos critérios estabelecidos em Normas Nacionais e Internacionais como a RDC 665:2022 da Anvi- Profª. Dra. Isabela Rodrigues Olívio Cirurgiã-Dentista Universidade de São Paulo (USP) Mestra em Ciências Odontológicas Universidade de São Paulo (USP) Doutora em Reabilitação Oral Universidade de São Paulo (USP) Especialista em Implantodontia (ABO) Pós Graduada em Pesquisa Clínica (Invitare) sa, ISO13485:2016 e a ABNT ISO 14644:2019.
Todos os critérios estão estabelecidos em Procedimentos Operacionais e Instruções de Trabalho, documentos integrantes do arcabouço regulatório do Sistema de Gestão de Qualidade (SGQ) da empresa.
A IMPORTANCIA DO FLUXO LINEAR NA FABRICACAO DE DISPOSITIVOS MÉDICOS
A BYPRO Medical do Brasil garante um fluxo linear em seus processos de produção, evitando a contaminação cruzada e proporcionando:
Segurança e proteção: ao reduzir a contaminação cruzada, há uma proteção maior contra a propagação de patógenos, alérgenos, substâncias químicas e outras impurezas indesejadas.
Qualidade e conformidade: Ao implementar um fluxo linear que evita a contaminação cruzada, é possível manter um alto nível de qualidade e conformidade com regulamentações e padrões aplicáveis. Isso é particularmente importante no setor de Dispositivos Médicos em que a BYPRO Medical do Brasil atua, onde a contaminação cruzada pode comprometer o desempenho final dos produtos.
Produtividade e eficiência: Um fluxo linear bem delineado contribui para a melhoria da produtividade e eficiência dos processos implementados. Ao evitar a interrupção causada por contaminação acidental, as operações fluem de maneira mais suave, reduzindo retrabalhos, perdas de tempo e custos associados, reduzindo desperdícios e garantindo mais sustentabilidade.
Preservação da reputação e imagem da marca: A ocorrência de contaminação pode levar a recalls de produtos, perda de confiança dos consumidores e danos à reputação da empresa. O fluxo implementado e seguido pela BYPRO Medical do Brasil minimiza essa possibilidade, demonstrando um compromisso com a qualidade, segurança e responsabilidade, contribuindo para a preservação da reputação da marca.


Referências:
ABNT NBR ISO 14644-1:2019 - Salas
Limpas e Ambientes Controlados
Associados - Parte 1 - Classificação de
Limpeza do Ar
Documento SGQ BYPRO - F.13.1
Controle Estatístico de Monitoramento
Ambiental e Microbiológico
Documento SGQ BYPRO - IT 03
Limpeza da Sala Limpa
Documento SGQ BYPRO - POP 13
Controle Ambiental
https://asmontec.com.br/salas-
-limpas/
https://www.airlinkfiltros.com.br/
artigos/explicando-o-conceito-de-
-salas-limpas-areas-criticas-e-areas-
-limpas/
Institucional BYPRO Medical do
Brasil
ISO 10993-1:2018 - Biological
evaluation of medical devices
ISO13485:2016 - Dispositivos médicos
– Gestão de qualidade
ISO 14644-3:2019 - Salas Limpas e
Ambientes Controlados Associados -
Parte 3 – Métodos de Ensaio
Normas e tecnologias empregadas
em salas limpas da indústria farmacêutica
(www.ictq.com.br)
RDC Nº 665:2022 - Boas Práticas
de Fabricação de Produtos Médicos
e Produtos para Diagnóstico de Uso
In Vitro

Profª. Dra. Isabela Rodrigues Olívio
Cirurgiã-Dentista
Universidade de São Paulo (USP)
Mestra em Ciências Odontológicas
Universidade de São Paulo (USP)
Doutora em Reabilitação Oral
Universidade de São Paulo (USP)
Especialista em Implantodontia (ABO)
Pós Graduada em Pesquisa
Clínica (Invitare)
